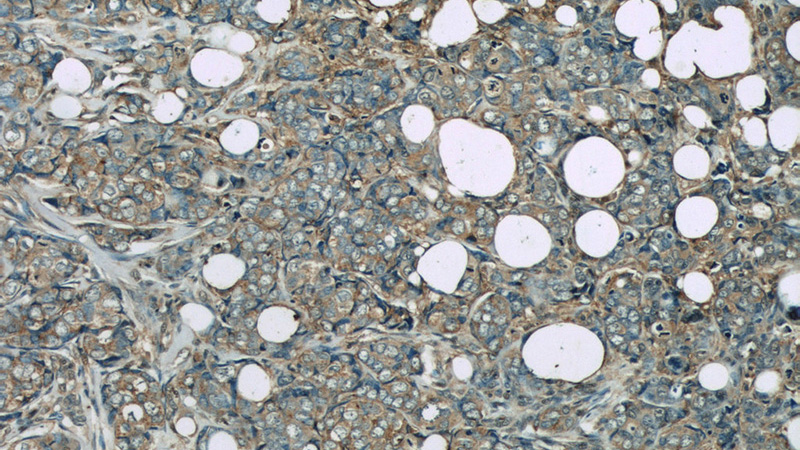
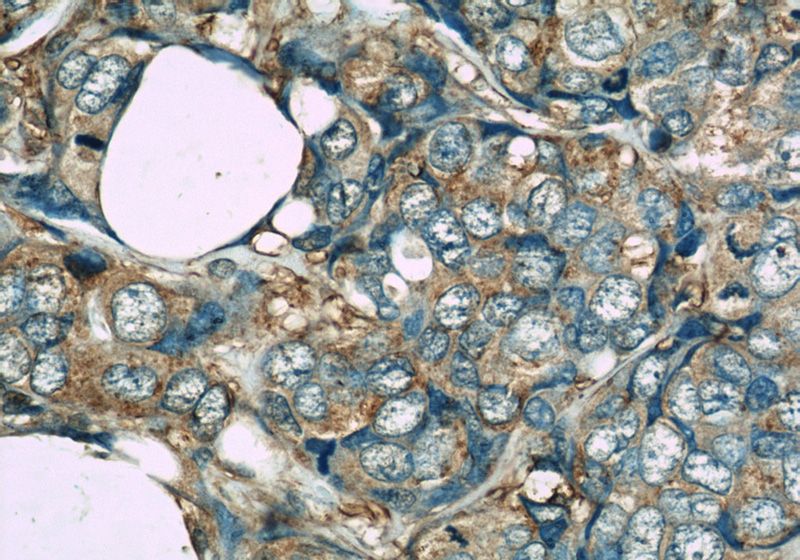

-
Product Name
GAPDH antibody
- Documents
-
Description
GAPDH Mouse Monoclonal antibody. Positive WB detected in multi-cells/tissue, arabidopsis whole plant tissue, corn whole plant tissue, HEK-293 cells, HeLa cells, Raji cells, rice whole plant tissue, soybean whole plant tissue, wheat whole plant tissue, whole Nematode tissue, whole yeast cells, zebrafish tissue. Positive IP detected in HeLa Cells. Positive FC detected in HeLa cells. Positive IHC detected in human breast cancer tissue, human kidney tissue. Positive IF detected in Ethacrynic acid treated HeLa cells. Observed molecular weight by Western-blot: 36 kDa
-
Tested applications
ELISA, WB, IF, FC, IP, IHC
-
Species reactivity
Human, Mouse, Rat, Zebrafish, Yeast; other species not tested.
-
Alternative names
G3PD antibody; GAPD antibody; GAPDH antibody; OK/SW cl.12 antibody
-
Isotype
Mouse IgG2b
-
Preparation
This antibody was obtained by immunization of GAPDH recombinant protein (Accession Number: NM_001289745). Purification method: Protein A purified.
-
Clonality
Monoclonal
-
Formulation
PBS with 0.1% sodium azide and 50% glycerol pH 7.3.
-
Storage instructions
Store at -20℃. DO NOT ALIQUOT
-
Applications
Recommended Dilution:
WB: 1:5000-1:20000
IP: 1:3000-1:20000
IHC: 1:20-1:200
IF: 1:20-1:200
-
Validations

Western blot analysis of GAPDH in various tissues and cell lines using Proteintech antibody Catalog No:117316 at a dilution of 1:10000.

Western blot of Hela cell with anti-GAPDH (Catalog No:117316) at various dilutions.

IP result of anti-GAPDH (Catalog No:117316 for IP and Detection) with HeLa cell lysate.
Immunohistochemistry of paraffin-embedded human breast cancer slide using Catalog No:117316(GAPDH Antibody) at dilution of 1:50
Immunohistochemistry of paraffin-embedded human breast cancer slide using Catalog No:117316(GAPDH Antibody) at dilution of 1:50

Immunofluorescent analysis of Ethacrynic acid treated HeLa cells using Catalog No:117316(GAPDH Antibody) at dilution of 1:50 and Rhodamine-labeled goat anti-mouse IgG (red).

1X10^6 HeLa cells were stained with 0.2ug GAPDH antibody (Catalog No:117316, red) and control antibody (blue). Fixed with 90% MeOH blocked with 3% BSA (30 min). FITC-Goat anti-Mouse IgG with dilution 1:100.
-
Background
Glyceraldehyde-3-phosphate dehydrogenase (GAPDH) catalyzes the phosphorylation of glyceraldehyde-3-phosphate during glycolysis. GAPDH participates in nuclear events including transcription, binding RNA, RNA transportation, DNA replication, DNA repair and apoptosis. Being stably and constitutively expressed at high levels in most tissues and cells, GAPDH is considered a housekeeping protein. It was widely used as a control for RT-PCR and also loading control in electrophoresis and Western blotting. GAPDH is normally expressed in cellular cytoplasm or membrane, but can occasionally translocate to the nucleus post modification such as S-nitrosylation. This antibody is a mouse monoclonal antibody raised against full length GAPDH of human origin. It can recognize the 36kda GAPDH protein in most cells/tissues. Please note that some physiological factors, such as hypoxia and diabetes, increase GAPDH expression in certain cell types. Read more about this antibody on the blog:http://blog.ptglab.com/index.php/gapdh-antibody-success-in-silkworm/
-
References
- Han J, Li L, Hu J. Epidermal growth factor stimulates human trophoblast cell migration through Rho A and Rho C activation. Endocrinology. 151(4):1732-42. 2010.
- Xie G, Zhu X, Li Q. SZ-685C, a marine anthraquinone, is a potent inducer of apoptosis with anticancer activity by suppression of the Akt/FOXO pathway. British journal of pharmacology. 159(3):689-97. 2010.
- Liu X, Feng R, Du L. The role of enoyl-CoA hydratase short chain 1 and peroxiredoxin 3 in PP2-induced apoptosis in human breast cancer MCF-7 cells. FEBS letters. 584(14):3185-92. 2010.
- Liu X, Feng R. Inhibition of epithelial to mesenchymal transition in metastatic breast carcinoma cells by c-Src suppression. Acta biochimica et biophysica Sinica. 42(7):496-501. 2010.
- Liu A, Tang M, Xi J. Functional characterization of inward rectifier potassium ion channel in murine fetal ventricular cardiomyocytes. Cellular physiology and biochemistry : international journal of experimental cellular physiology, biochemistry, and pharmacology. 26(3):413-20. 2010.
- Liu G, Guo H, Guo C, Zhao S, Gong D, Zhao Y. Involvement of IRE1α signaling in the hippocampus in patients with mesial temporal lobe epilepsy. Brain research bulletin. 84(1):94-102. 2011.
- Huo SJ, Li Y, Raisman G, Yin ZQ. Transplanted olfactory ensheathing cells reduce the gliotic injury response of Müller cells in a rat model of retinitis pigmentosa. Brain research. 1382:238-44. 2011.
- Zeng R, Wang LW, Hu ZB. Differentiation of human bone marrow mesenchymal stem cells into neuron-like cells in vitro. Spine. 36(13):997-1005. 2011.
Related Products / Services
Please note: All products are "FOR RESEARCH USE ONLY AND ARE NOT INTENDED FOR DIAGNOSTIC OR THERAPEUTIC USE"
